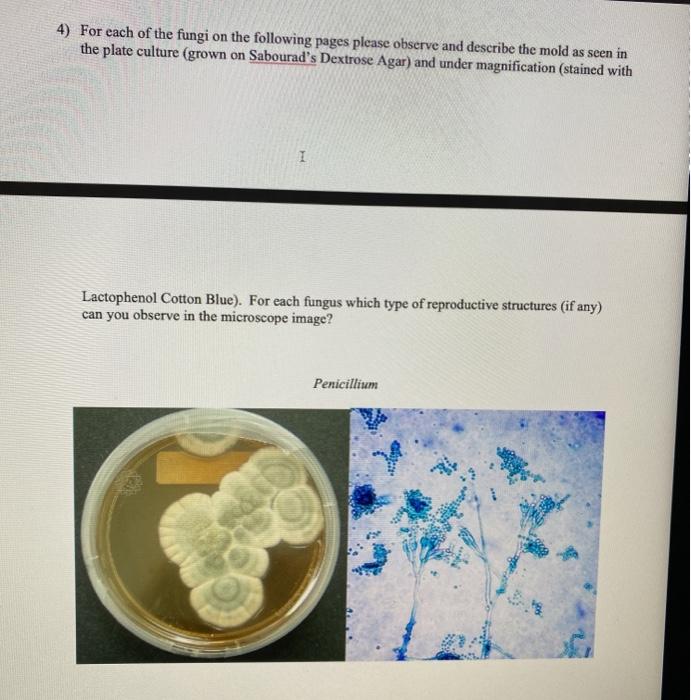

43 how does mold reproduce
Reproduction - BioWeb Home Under favorable conditions, plasmodial slime molds reproduce by forming a reproductive stalk containing spores. This reproductive stalk looks spherical or even popsicle-like on top. When the time is right, these stalks will release the spores and new slime molds will proliferate. The time is right when there How Does Mold Grow and Reproduce? Minute and threadlike, hypha cells feed on organic matter, absorbing nutrients and forming clusters - the visible evidence of mold. Like roots, they anchor mold to its substrate, providing nutrients. Wiping down surfaces does nothing to detract these cells from reproducing and returning. 2. Mighty Morphing Mycelium The hyphae morph into mycelium.
Mold Course Chapter 1: | US EPA 13 Jul 2021 — Molds can multiply by producing microscopic spores (2 - 100 microns [µm] in diameter), similar to the seeds produced by plants.

How does mold reproduce
What is the Life Cycle for Mold? - Stern Mold • As spores settle in and begin reproducing, the mold life cycle comes full circle. The spores absorb moisture and nutrients from their new home and begin generating new hyphae. Left unchecked, the process continues indefinitely. How the mold life cycle affects mold treatment The Life Cycle of Mold: How This Fungi Grows - QIPA Molds reproduce by forming small airborne spores. Due to their small microscopic size, mold has the ability to travel through several mediums like air, water, and mold bearing insects. Once these organisms come into contact with a surface that has the ideal conditions present (primarily moisture), the life-cycle begins. How Is Mold - Everything Inc. How Is Mold. Molds thrive on moisture and reproduce by means of tiny, lightweight spores that travel through the air. You're exposed to mold every day. In small amounts, mold spores are usually harmless, but when they land on a damp spot in your home, they can start to grow.
How does mold reproduce. How Mold Reproduces - Water Damage Molds reproduce by producing microscopic spores that travel through indoor and outdoor air easily with just a passing breeze. The spores themselves are found everywhere in dust and throughout the air. But indoor mold only grows when there is added moisture like from a damp spot. As molds grow they digest what they are growing on. How Does The Slime Mold Reproduce? - sonalsart.com Does mold reproduce? Mold reproduces via the production of small spores. These spores can be compared to the seeds of a plant, though they are much smaller than seeds or even pollen grains. Their small size makes them easy to disperse via wind and water. Related question for How Does The Slime Mold Reproduce? mold - Students | Britannica Kids | Homework Help Most molds can reproduce both asexually and sexually. Asexual reproduction can occur by fragmentation—if the mycelium is physically separated, many of the ... When do molds reproduce? - Movie Cultists How does a Molds reproduce? ... Mold reproduces via the production of small spores. These spores can be compared to the seeds of a plant, though they are much ...
Black Mold - Pictures, Causes and Signs (Ultimate Guide) Black mold releases toxic spores that linger in the air and attack your respiratory health. The potency of these toxic spores has proved to be the most detrimental to human health. Black mold often appears as slimy and greenish-black. If its water source runs out, black mold can also appear as dry and powdery. How Does Bread Mold Reproduce? - Reference.com Bread mold reproduces asexually, using mitosis to form spores, and sexually. Sexual reproduction involves contact between opposite mating strains of the fungus to form a zygospore. Bread mold, Rhizopus stolonifer, most often reproduces asexually. 8.3: Molds - Biology LibreTexts 3 Jan 2021 — 1. Molds reproduce primarily by means of asexual reproductive spores (Figure 8.3.1). These include the following. a. conidiospores (conidia) See ... Does slime mold reproduce sexually or asexually? - Board ... Some slime molds reproduce asexually using spores, much like fungi, but other kinds reproduce sexually, fusing gamete cells to form zygotes (the earliest stage of an embryo). Now both types of slime molds (plasmodial slime mold and cellular slime mold) are classified in the Amoebozoa kingdom.
What Causes Mold Growth? Mold spores can perform asexual reproduction by mitosis or meiosis. Mitosis and meiosis are the two types of cell division that cause molds to grow and ... How does a water mold reproduce? - FindAnyAnswer.com Water Mold is unique in the sense that it can reproduce both sexually and asexually. This process can be as simple as a division of a sporangium into individual motile, flagellated spores, or as intricate as a sexual process. This special part is what enables some Water Mold to reproduce sexually. Click to see full answer How do Mould Mushroom Moss Fern reproduce? Answers Mushrooms, ferns and mould reproduce from spores. Spore formation is a part of asexual reproduction. They are unicellular bodies. Spores can be found in a sac known as sporangia. When it gets mature, it bursts open. Ferns, mushrooms and moulds are reproduced through this method. How does a slime mold reproduce? - Colors-NewYork.com Under favorable conditions, plasmodial slime molds reproduce by forming a reproductive stalk containing spores. This reproductive stalk looks spherical or even popsicle-like on top. When the time is right, these stalks will release the spores and new slime molds will proliferate. Do slime molds reproduce asexually?
Black Bread Mold - Biology Wise Black bread mold can also reproduce using sexual production. Also, this mold has two mating types referred as '+' and '-'. When pheromones are released by these two types, they trigger the hyphae to grow sideways so that these two types can meet.
Do Mold Spores Ever Die? Is it Possible to Kill Them ... Depending on the species of mold, some spores can remain dormant for hundreds of years. While mold spores are highly durable, there are ways that you can significantly improve indoor air quality (IAQ). In order to have a better understanding of how to improve IAQ, you first need to know how mold spores reproduce. The Life Cycle of Mold
How do molds reproduce? - Answers How do molds reproduce? - Answers Mold reproduces by releasing spores which float in the air or are passed along by humans or animals, or anything that passes by that it can cling onto and then if...
Molds are able to reproduce sexually: Researchers grow ... For over 100 years, it was assumed that the penicillin-producing mold fungus, Penicillium chrysogenum, only reproduced asexually through spores. Biologists have now shown for the first time that ...
How does water mold reproduce? - Rehabilitationrobotics.net Water molds reproduce sexually when an egg cell is fertilized by a sperm nucleus, forming a diploid zygote. When conditions are favorable, the zygote releases motile spores with two flagella. What are the general characteristics of water molds? The water molds resemble other fungi because they have branched filaments and form spores.
Rhizopus stolonifer- Black Bread Mold Reproduction Reproduction: Rhizopus stolonifer style Rhizopus stolonifer exhibits both sexual and asexual reproduction. The asexual phase occurs more frequently. The surrounding condition in which the mold resides, is the factor that causes either type of reproduction by the mold.
How do Yeast & Molds Reproduce Flashcards - Quizlet Start studying How do Yeast & Molds Reproduce. Learn vocabulary, terms, and more with flashcards, games, and other study tools.
How Does Water Mold Reproduce (With Helpful Tips And ... Asexual and sexual reproduction is both possible for water molds. It just varies because of the species and the factors that are necessary for the reproduction process. Asexual reproduction Sporangium is a structure that produces spores, which plays a vital role in the asexual reproduction of water molds.
Mold - Wikipedia Molds reproduce by producing large numbers of small spores, which may contain a single nucleus or be multinucleate. Mold spores can be asexual (the products of mitosis) or sexual (the products of meiosis ); many species can produce both types.
How does a slime mold move? - FindAnyAnswer.com They reproduce through spores. However, there is one big difference between slime molds and fungi: slime molds move. A slime mold streams over bark and leaves, engulfing them. While it moves like an animal, it acts like a fungus. Similarly, how fast does slime mold move? This giant cell moves, but only pictures taken over several days can show ...
How does Stachybotrys chartarum reproduce? Black mold (Stachybotrys chartarum) reproduces primarily asexually producing millions of tiny spores. Click to read full detail here. Similarly, it is asked, how long does it take for Stachybotrys to grow? eight to twelve days Similarly, is Stachybotrys common? Most Stachybotrys species inhabit materials rich in cellulose.
how does mushroom reproduction differ from yeast and mold ... How does mold reproduce? Mold reproduces via the production of small spores. These spores can be compared to the seeds of a plant, though they are much smaller than seeds or even pollen grains. Their small size makes them easy to disperse via wind and water. They can also travel long distances by clinging on to clothing or fur.
Mold And Mycotoxins - You Are The Healer They reproduce using both sexual and asexual methods. Molds may produce mycotoxins which can be harmful to our health as well as our animal's health. Mycotoxins Made By Mold When under the right conditions, as molds grow, some molds may produce potentially toxic byproducts and these are called mycotoxins.
How Is Mold - Everything Inc. How Is Mold. Molds thrive on moisture and reproduce by means of tiny, lightweight spores that travel through the air. You're exposed to mold every day. In small amounts, mold spores are usually harmless, but when they land on a damp spot in your home, they can start to grow.
The Life Cycle of Mold: How This Fungi Grows - QIPA Molds reproduce by forming small airborne spores. Due to their small microscopic size, mold has the ability to travel through several mediums like air, water, and mold bearing insects. Once these organisms come into contact with a surface that has the ideal conditions present (primarily moisture), the life-cycle begins.
What is the Life Cycle for Mold? - Stern Mold • As spores settle in and begin reproducing, the mold life cycle comes full circle. The spores absorb moisture and nutrients from their new home and begin generating new hyphae. Left unchecked, the process continues indefinitely. How the mold life cycle affects mold treatment

0 Response to "43 how does mold reproduce"
Post a Comment